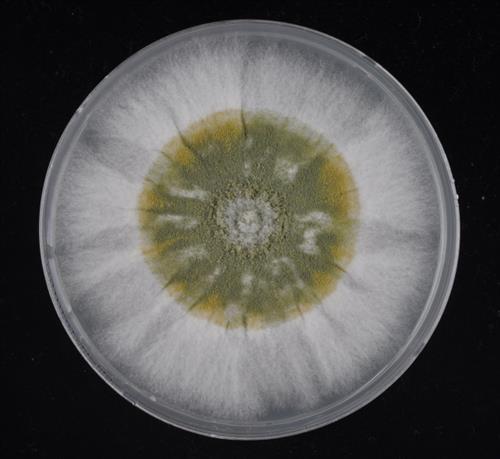

![]() |
| △ 강원도 동해에서 확보한 막걸리 및 전통주 제조용 균주. |
막걸리 종주국 자존심 찾았다…전통 균주 3종 확보
국립생물자원관 특허출원…일본산 대체 가능성 커
(세종=연합뉴스) 이상헌 기자 = 막걸리 제조에 사용되는 쌀알누룩 균주가 국내에서 확보됐다. 지금까지는 일본산 균주를 주로 사용해 왔다.
국립생물자원관은 김계원 한경대 교수, 이인원 서울대 교수, 박천석 경희대 교수 등과 공동연구를 통해 전통 누룩 27종에서 미생물자원 212종의 균주를 확보하고 이 중 양조 특성에 맞는 우수 균주 3종을 특허 출원했다고 25일 밝혔다.
누룩곰팡이의 일종인 우수 균주 3종은 전남 고흥군, 강원 정선군과 동해시에서 각각 수집한 누룩에서 분리한 것들이다.
이들 균주는 과일이나 꽃 등 독특한 향과 풍부한 맛을 갖고 있는데다 인체에 유해한 독소를 생성하지 않는 것으로 확인돼 입국(立麴·찐 쌀에 균주를 배양한 쌀알누룩)용 종균으로 개발될 가능성이 크다고 자원관은 설명했다.
현재 국내 막걸리에 사용되는 입국용 종균은 과거 일본에서 도입된 백국균으로 국내에서 증식·배양해 업체들이 사용하고 있다. 로열티를 내는 것은 아니다.
물론 일부 업체가 전통 누룩을 사용하긴 하지만 품질관리의 어려움과 영세성 때문에 백국균에서 배양한 발효제를 주로 사용하는 실정이다.
하지만, 이들 균주가 유전자 분석을 통해 우리나라 자생 미생물자원으로 확인된 만큼 생물자원에 대한 권리를 주장할 수 있는 기틀이 마련됐다는 평가다.
김상배 생물자원관장은 "전통주 제조업체에 우선 보급해 막걸리나 전통주 제조에 사용되도록 기술 이전을 추진하겠다"고 말했다.
생물자원관은 이들 균주 3종 외에도 지방분해 및 미백에 효과가 있는 균주에 대해 화장품과 기능성식품, 의약품 등 다른 생물산업 소재로 연구를 확대할 계획이다.
[저작권자ⓒ 상주부자동네카임즈. 무단전재-재배포 금지]